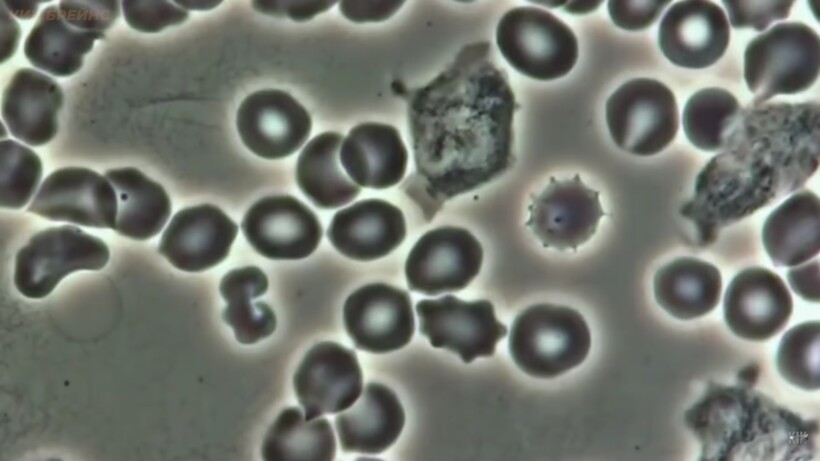

Бактерии, найденные подо льдами Антарктиды, могут иметь внеземное происхождение.
Большинство людей считает, что Антарктида — это холодный необитаемый континент, который состоит только изо льда. На самом деле на этом континенте находятся исследовательские базы, которые напоминают небольшие деревни со своей инфраструктурой. Количество жителей холодного континента изменяется в зависимости от времени года, но среднее число живущих среди льдов составляет около тысячи человек.

Ученые ежедневно занимаются исследованием различных явлений в Антарктиде. Антарктиду покрывает несколько слоев льда, под которыми, как оказалось, скрывается много интересного. Не так давно в толщах льда были обнаружены озера и самый большой кратер на поверхности нашей планеты, который остался от гигантского метеорита, погубившего динозавров миллионы лет назад. Совсем недавно исследователи заметили странные микроорганизмы, живущие при экстремально низкой температуре.
Эти бактерии были обнаружены во льдах, возраст которых составляет 5 тысяч лет. Самое интересное заключается в том, что микробы жизнеспособны. Так как открытие было сделано совсем недавно, биологи еще не успели придумать название для странных бактерий. По некоторым данным, они имеют внеземное происхождение. Что же заставило ученых предположить, что эти микробы попали на Землю из космоса?

Проведенный анализ показал, что строение этих микроорганизмов только на 86 процентов совпадает со строением земных микробов, известных науке. Эта находка может рассказать многое о том, какой была планета миллионы лет назад и сделать предположения по поводу строения внеземных организмов. Похожие бактерии обнаружили в ледяных озерах на глубине 3500 метров. Пока у ученых нет подтверждения того, что микробы родом с другой планеты, но их состав не похож ни на один вид существующих на Земле бактерий. А как вы считаете, откуда взялись подо льдами загадочные бактерии?
О том, что еще находится подо льдами Антарктиды, вы можете узнать из другого нашего материала.
Присоединяйся к нашему сообществу в телеграмме, нас уже более 1 млн человек 😍
Ссылка на тематические чаты тут https://t.me/+69dR1AvDfdM0MTYy